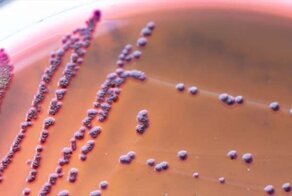
Рассказ о животных с гиперспособностями

Кто бы мог подумать, что какое-то маленькое недоразумение с идиотской внешностью может убить тебя быстрее, чем ты успеешь над ним посмеяться.

Голый землекоп проходит сквозь бетонную стену

Голый землекоп выглядит как идеальный герой американского мультсериала – этакий нелепый и абсолютно тупой персонаж. Чем дольше вы на «это» смотрите, тем глупее оно вам кажется.
Сначала в глаза бросаются торчащие передние зубы, из-за которых кажется, будто животное постоянно растерянно улыбается. Потом, приглядевшись, понимаешь, что под ними начинается ещё один ряд зубов.
Только взгляните на это жалкое существо! Кажется, будто оно несколько часов проспало в ванной большой коммуналки, а теперь объясняется с разъяренными соседями, которые его, наконец, добудились.

Эта бледная сморщенная кожа тоже работает на образ депрессивного нелюдима, который не выбирался в свет уже… да, собственно, никогда. Что очень близко к истине, поскольку землекопы живут в подземных туннелях, где и производят себе подобных.
Суперспособность:
Передние зубы голого землекопа – страшное оружие. Они позволяют животному в буквальном смысле проходить сквозь толщу бетона. Вот как это выглядит:
Так было до:

И вот что стало после:

Как это возможно? Во-первых, зубы землекопа твёрдые, как алмаз, во-вторых, безупречную работу челюсти обеспечивают 25 процентов его мускулов (у человека, для сравнения, это только один процент).
Кроме того, на способность грызть, грызть и грызть работает треть коры головного мозга этой твари. То есть эволюция «забила» на усовершенствование остальных частей организма этих животных, и направила все силы в область челюсти. Если бы природа с тем же усердием поработала над остальными органами голых землекопов… мало бы нам точно не показалось.

Чтобы рыть просторные подземные туннели и выкапывать еду, землекопам даже дарована способность управлять передними зубами по отдельности – примерно как китайскими палочками.
Конечно, даже после всего вышесказанного голый землекоп не стал симпатичнее, но уж нелепым безобидным созданием его тоже вряд ли теперь назовёшь.
Аксолотль способен отрастить себе новый мозг

Это существо тоже очень напоминает мультгероя студии Pixar. Тем не менее, оно очень даже настоящее. По-научному называется albino axolotl. Кажется, будто природа создала его на скорую руку из оставшихся невостребованными деталей – тело как у рыбы, лягушачьи лапки и физиономия Покемона:

И последний штрих – кисточки от скатерти вокруг головы
Несмотря на такие внешние данные, аксолотль не имеет ничего общего ни с рыбами, ни с лягушками – это саламандра, которая водится в мексиканских озёрах.

Суперспособность:
У аксолотля такой дар – обзавидуешься: фантастическая способность отращивать утраченные органы.
Мы, конечно, знаем и других животных, которые могут отращивать новые хвосты или лапы, но всем им до аксолотля очень-очень далеко: он умеет полностью восстанавливать не только конечности, но и глаза, челюсти, сердце. И наконец – это единственное позвоночное, которое может заново отрастить повреждённые фрагменты своего мозга. Есть у них и ещё одна фирменная фишка. Иногда они теряют одну конечность, а отращивают две – чтобы, как говорится, было.

Что касается нелепого внешнего вида, он как раз полностью соответствует содержанию, поскольку эти создания, вдобавок ко всему, могут буквально собирать себя по частям – присоединяя к себе освободившиеся части других сородичей – включая головы.
Грубо говоря, если взять куски аксолотлей, сложить вместе и перемешать, то вполне возможно (утверждать наверняка не берёмся), что этот винегрет вскоре срастётся в нечто единое, поднимется на лапы и отправится по своим аксолотским делам.

Благодаря своим уникальным способностям, эти животные водятся теперь не только в Мексике – их можно найти в научных лабораториях по всему миру, где учёные беспрестанно режут их на кусочки и потом опять складывают, как мозаику, надеясь разгадать этот фокус-покус.
3. Рыба-слон видит вас насквозь (или, по крайней мере, чует)

Рыба-слон получила своё название по недоразумению. Её похожий на хобот нарост имеет отношение не к носу, а к подбородку. Эта рыба проводит большую часть своей жизни в кромешной темноте, делая вылазки исключительно по ночам.
Суперспособность:
Эта штуковина на голове на самом деле выполняет функцию персонального металлоискателя. С его помощью рыба находит добычу, даже если та зароется в ил или спрячется в темноте. Этот «детектор» образует электрическое поле, которое искажается находящимися поблизости объектами, что позволяет слепой рыбе «видеть» всё, что происходит вокруг. Этакий полукиборг водного мира.

При помощи такого бесценного инструмента рыба-слон может получить точную информацию о форме и размерах любого находящегося поблизости объекта, а также определить расстояние до него с точностью до нескольких миллиметров. Проплывая над самым дном, рыба-слон с лёгкостью находит микроскопических насекомых и устанавливает, живые они или мёртвые – есть и такая функция. Что важно, потому что рыба-слон питает слабость к мёртвым личинкам.

Кроме того, этот странный орган используется и для спаривания. Каждый подвид рыбы-слона имеет свой электрический заряд. Самки их различают и отдают предпочтение представителям собственного подвида.
Антилопа-прыгун умеет перескакивать со скалы на скалу

Антилопа-прыгун (или клиппшпрингер; прим. mixstuff.ru) – разновидность африканских антилоп, которые ходят «на цыпочках», будто бояться кого-то разбудить. И вообще, у них вечно настолько жеманный вид – кажется, вот-вот тушь потечёт.

Конечно, про всех копытных животных можно сказать, что они ходят на цыпочках, но прыгуны единственные, кто касается земли только кончиками «пальцев»: они напоминают балерин на пуантах, и кажутся такими же хрупкими.

Суперспособность:
Именно эти «пуанты» позволяют антилопам совершать вполне балетные по красоте и лёгкости прыжки с камня на камень. Только поглядите, что вытворяют
И это ещё что – они могут подпрыгивать на головокружительную высоту – в 15 раз превышающую их собственный рост. Обратили внимание, как близко располагаются ноги животного, когда оно приземляется? Это не случайно: копыта позволяют им удерживаться на поверхности не больше юбилейной монеты, всеми четырьмя ногами. Поэтому антилопы-прыгуны могут добираться до таких вершин, которые никому больше не покоряются.

Секрет заключается в своеобразном каучукоподобном слое, которым снизу покрыты копыта антилоп. Он позволяет животным перескакивать с камня на камень и не скользить. Или стоять на любой поверхности – против, казалось бы, всех законов природы.

Тихоокеанский кальмар умеет летать

В океане полно существ, которые для нас выглядят совершенно идиотски. Всё склизкое и странно-оформленное снабжено большими грустными глазами. Акулам невдомёк, как им повезло. Взгляните, к примеру, на этого бедолагу:

Эти оранжевые штуковины – не щупальца, как можно было бы подумать. Это усы-руль. А колбаска, которая к нему подсоединена – это не что иное, как летящий тихоокеанский кальмар.
Суперспособность:
Эти летающие кальмары сфотографированы у берегов Японии:

Для того чтобы вытолкнуть себя из воды они (извините за неблагозвучность) пукают. Делается это так: кальмар втягивает в себя как можно больше воды, потом выталкивает её из себя, да с таким напором, что… обретает радость полёта. Причём биологи настаивают, что это не прыжок и не скольжение, а именно самый что ни на есть настоящий полёт.
Кальмары могут подниматься над водой почти на 20 метров и проделывать по воздуху путь до 45 метров за раз, при этом над водой они передвигаются в пять раз быстрее, чем в воде.

Плавники, которые на время полёта становятся крыльями, расположены у кальмара в задней части, поэтому летать приходится хвостом вперёд. И полёты для них не просто развлечение – они позволяют сэкономить уйму времени и сил во время миграций. Кальмары, как и их родственники-осьминоги, умирают вскоре после спаривания – а это серьёзный повод поторопиться.
Летающие кальмары не так известны, как летающие рыбы – главным образом, потому, что предпочитают проводить «самозапуски» ночью, когда любопытных глаз и голодных птиц не так много.

Источник: mixstuff.ru
- 7 существ, которых природа наделила сверхспособностями
- Удивительные животные, которые поражают своими суперспособностями
- Люди Икс: российская версия
- Рассказ о животных с гиперспособностями
- Неприлично длинные языки: красота или уродство?

Аксолотль, конечно, что-то чересчур... не верится
А это землекопское ***ище не надо никому показывать - страшно)